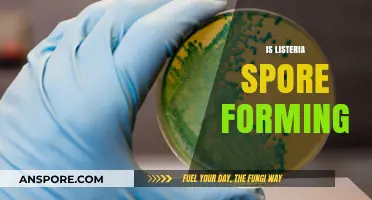
Listeria Spore Formation: Unraveling the Truth Behind This Foodborne Pathogen

Milky spore, a naturally occurring bacterium scientifically known as *Paenibacillus popilliae*, has been widely discussed as a biological control method for Japanese beetle grubs, which are notorious lawn pests. Its effectiveness lies in its ability to infect and kill the grubs during their larval stage, thereby reducing future beetle populations. While many gardeners and lawn care enthusiasts praise milky spore for its eco-friendly and long-lasting effects, its success depends on factors such as soil temperature, moisture, and proper application. Studies suggest that it may take several years to establish in the soil, and results can vary based on environmental conditions. Despite this, milky spore remains a popular alternative to chemical pesticides for those seeking sustainable pest management solutions.
| Characteristics | Values |
|---|---|
| Effectiveness Against Japanese Beetles | Highly effective in reducing Japanese beetle grub populations in lawns. |
| Mode of Action | Milky Spore (Paenibacillus popilliae) infects and kills grubs in the soil. |
| Longevity | Can remain active in the soil for up to 20 years after application. |
| Environmental Impact | Safe for humans, pets, and beneficial insects; eco-friendly. |
| Application Timing | Best applied in late summer or early fall when grubs are actively feeding. |
| Effect on Adult Beetles | Does not directly affect adult Japanese beetles. |
| Reapplication Needed | Rarely needed due to its long-lasting effects. |
| Cost | Moderate initial cost but cost-effective long-term. |
| Effectiveness in Severe Infestations | May require multiple applications or complementary methods for severe cases. |
| Temperature Sensitivity | Works best in soils with temperatures between 60°F and 70°F. |
| Compatibility with Other Treatments | Can be used alongside other organic lawn care methods. |
| Availability | Widely available in garden centers and online stores. |
| User-Friendliness | Easy to apply with basic gardening tools. |
| Scientific Backing | Supported by numerous studies and decades of use. |
What You'll Learn

Milky Spore's effectiveness against Japanese beetles
Milky Spore, a biological insecticide containing the bacterium *Bacillus popilliae*, targets Japanese beetle grubs in their larval stage. Applied to soil, it infects and kills the grubs, disrupting their life cycle. The bacterium persists in the soil for years, offering long-term control. However, its effectiveness hinges on specific conditions: soil pH (6.0–8.5), moisture, and temperature (above 60°F). Misapplication or adverse conditions can render it ineffective, making it a nuanced solution rather than a universal fix.
To maximize Milky Spore’s effectiveness, follow these steps: apply 1 teaspoon per 10 square feet of lawn, evenly distributing it across the affected area. Water thoroughly after application to activate the spores and ensure soil penetration. Reapply every 2–3 years to maintain spore populations. Avoid using chemical pesticides concurrently, as they can kill the beneficial bacteria. Best results occur when applied in late summer or early fall, when grubs are actively feeding near the soil surface.
Comparing Milky Spore to chemical pesticides reveals its strengths and limitations. While chemical treatments offer quick results, they often harm beneficial insects and pollute soil and water. Milky Spore, in contrast, is safe for pets, humans, and the environment, but its action is slower and depends on grub presence. For severe infestations, combining Milky Spore with nematodes (*Heterorhabditis bacteriophora*) can enhance effectiveness, as nematodes target grubs in cooler soil conditions where bacteria may struggle.
A critical factor in Milky Spore’s success is community effort. Japanese beetle grubs don’t respect property lines, so isolated applications may yield limited results. Neighborhood-wide treatment increases spore spread and reduces reinfestation. Additionally, monitor soil pH and amend with lime if acidic, as *Bacillus popilliae* thrives in neutral to slightly alkaline conditions. Patience is key—visible reduction in adult beetles may take 2–3 years as the grub population declines.
Practical tips include testing soil pH before application and avoiding overwatering, which can wash spores away. For new lawns, apply Milky Spore before sodding or seeding to establish a protective barrier. While not a quick fix, Milky Spore offers a sustainable, eco-friendly approach to Japanese beetle control, particularly when paired with cultural practices like proper lawn irrigation and reducing thatch buildup. Its effectiveness lies in its persistence and safety, making it a valuable tool for long-term pest management.
Do Spores Contain Nutrients? Unlocking Their Nutritional Potential
You may want to see also

Application timing for optimal milky spore results
Milky spore, a bacterium targeting Japanese beetle grubs, thrives on precise timing for maximum impact. Apply it when grubs are actively feeding—typically late summer to early fall. This aligns with their life cycle, ensuring they ingest the spores during their most vulnerable stage. Miss this window, and you’ll wait another year for results, as the bacterium persists in soil but remains dormant without active hosts.
Consider soil temperature and moisture as critical partners in timing. Milky spore requires soil temperatures between 60°F and 70°F for optimal activation. Water the treated area lightly after application to help spores penetrate the soil, but avoid overwatering, which can dilute their concentration. For cooler climates, aim for early fall when temperatures are still favorable; in warmer regions, late summer applications work best.
Dosage matters, too. Apply 1 to 2 teaspoons of milky spore per square yard, evenly distributed across the lawn. For larger areas, use a spreader to ensure consistency. Reapply every 2 to 3 weeks for a total of three applications in one season to saturate the soil with spores. This builds a robust population capable of targeting future grub generations.
While milky spore is effective, it’s not instantaneous. Results appear gradually over 2 to 3 years as the bacterium establishes itself. Patience is key—don’t expect immediate grub eradication. Combine applications with cultural practices like proper watering and mowing to reduce beetle populations, as adult beetles lay eggs that become next year’s grubs.
Finally, monitor your lawn post-application. Look for reduced grub damage in subsequent years, such as fewer brown patches or less soil disruption from skunks and raccoons foraging for grubs. If damage persists, reassess timing and dosage, or consider complementary treatments like nematodes for faster control. Timing isn’t just a detail—it’s the linchpin of milky spore’s success.
Do Cocci Form Spores? Unraveling the Truth About These Bacteria
You may want to see also

Long-term impact of milky spore on soil health
Milky spore, a bacterium scientifically known as *Paenibacillus popilliae*, is widely recognized for its ability to control Japanese beetle larvae in lawns and gardens. However, its long-term impact on soil health extends beyond pest management. When applied correctly, milky spore persists in the soil for up to 20 years, continuously targeting grub populations without harming beneficial organisms. This longevity raises questions about its broader effects on soil ecosystems, particularly microbial diversity and nutrient cycling.
From an analytical perspective, milky spore’s specificity to Japanese beetle larvae minimizes disruption to non-target organisms, a stark contrast to chemical pesticides that often decimate beneficial soil life. Studies indicate that soils treated with milky spore maintain stable microbial communities, including fungi, bacteria, and nematodes essential for nutrient breakdown and soil structure. For instance, a 2018 study published in *Environmental Entomology* found no significant decline in earthworm populations in milky spore-treated soils, highlighting its compatibility with soil health. However, the bacterium’s persistence may slightly alter microbial dominance over time, favoring species that thrive in grub-reduced environments.
For gardeners and landscapers, integrating milky spore into soil management requires strategic application. The recommended dosage is 1 to 5 billion spores per acre, applied in late summer when grubs are actively feeding. To maximize efficacy and soil health benefits, combine milky spore with organic matter amendments like compost or manure. This dual approach not only enhances microbial activity but also improves soil structure and water retention. Avoid over-application, as excessive spores can lead to uneven distribution and reduced effectiveness.
A comparative analysis reveals that milky spore’s long-term presence in soil contrasts sharply with the transient effects of chemical pesticides. While chemicals degrade within months, leaving residues that can harm soil life, milky spore’s biological action aligns with sustainable soil management practices. For example, soils treated with milky spore often exhibit higher levels of organic carbon, a key indicator of soil fertility, compared to chemically treated plots. This suggests that milky spore not only controls pests but also contributes to long-term soil resilience.
In conclusion, the long-term impact of milky spore on soil health is overwhelmingly positive, provided it is used as part of a holistic soil management strategy. Its persistence, specificity, and compatibility with beneficial soil organisms make it a valuable tool for sustainable agriculture and gardening. By understanding its mechanisms and following best practices, users can harness milky spore’s benefits while fostering a thriving soil ecosystem. Practical tips include monitoring grub populations annually, rotating application areas, and pairing milky spore with organic soil amendments for optimal results.
Achieving Spore Testing Lab Accreditation: Essential Steps for Success
You may want to see also

Comparing milky spore to chemical pest control methods
Milky spore, a naturally occurring bacteria (Bacillus popilliae), targets Japanese beetle grubs in lawns, offering a biological alternative to chemical pesticides. Unlike broad-spectrum chemicals that kill a wide range of insects, milky spore specifically infects and eliminates grub larvae without harming beneficial organisms like earthworms or pollinators. This specificity makes it an attractive option for environmentally conscious homeowners. However, its effectiveness hinges on proper application and environmental conditions, such as soil moisture and temperature, which must remain consistent for the bacteria to thrive.
Chemical pest control methods, on the other hand, act quickly and are often more predictable in their results. Products like imidacloprid or carbaryl are applied as granules or sprays, providing immediate relief from grub infestations. These chemicals are systemic, meaning they are absorbed by the grass and ingested by the grubs, ensuring widespread coverage. However, their non-selective nature can lead to collateral damage, killing beneficial insects and potentially contaminating groundwater. Long-term use may also lead to resistance in pest populations, reducing their efficacy over time.
When comparing application methods, milky spore requires a more labor-intensive approach. It is typically applied in late summer or early fall, when grubs are actively feeding, using a spreader to distribute spores across the lawn. The recommended dosage is 1 to 2 teaspoons per 10 square feet, repeated every 2 to 4 weeks for the first year to establish the bacteria. Chemical treatments, however, often require a single application per season, making them more convenient for busy homeowners. Yet, this convenience comes at the cost of potential environmental and health risks, particularly for children and pets.
The long-term effectiveness of milky spore is one of its strongest selling points. Once established, the bacteria can persist in the soil for up to 20 years, providing ongoing protection against Japanese beetle grubs. Chemical treatments, while effective in the short term, degrade over time and require reapplication annually. This makes milky spore a more sustainable option, though its initial cost and slower action may deter those seeking immediate results. For those willing to invest time and patience, milky spore offers a safer, eco-friendly alternative to chemical pesticides.
In practice, the choice between milky spore and chemical methods depends on the severity of the infestation and the homeowner’s priorities. For mild to moderate grub problems, milky spore is a viable, long-term solution that aligns with organic lawn care practices. For severe infestations requiring rapid control, chemical treatments may be necessary, though their environmental impact should be carefully weighed. Combining both approaches—using chemicals for immediate relief followed by milky spore for long-term prevention—can also be a strategic middle ground. Ultimately, understanding the strengths and limitations of each method ensures informed decision-making for healthier lawns and ecosystems.
Unveiling Yeast Reproduction: Do They Form Spores to Multiply?
You may want to see also

Environmental benefits of using milky spore in gardens
Milky spore, a naturally occurring bacteria (Bacillus popilliae), targets Japanese beetle grubs in the soil, offering a targeted solution to a pervasive garden pest. Unlike broad-spectrum pesticides, it doesn’t harm beneficial insects, birds, or mammals, preserving the garden’s ecological balance. Applied at a rate of 1 to 2 teaspoons per 10 square feet, it forms a protective barrier that persists for up to 20 years, reducing the need for repeated chemical interventions. This specificity makes it an environmentally friendly alternative, minimizing collateral damage to non-target species.
Consider the lifecycle disruption milky spore introduces. By infecting and eliminating grubs, it prevents adult Japanese beetles from emerging, breaking the cycle of leaf damage and turf destruction. This reduction in beetle populations lessens the reliance on synthetic insecticides, which often leach into groundwater and harm pollinators. For gardeners, this means healthier plants and a reduced environmental footprint. Application is straightforward: water the lawn or garden bed before and after spreading the spores to activate them, ensuring they reach the soil where grubs reside.
From a comparative standpoint, milky spore stands out as a long-term, soil-based solution. Chemical treatments like carbaryl or imidacloprid offer quick fixes but degrade soil health over time, killing earthworms and microbes essential for nutrient cycling. Milky spore, on the other hand, enhances soil biodiversity by allowing beneficial organisms to thrive. It’s particularly effective in organic gardening, where synthetic chemicals are prohibited. For best results, apply in late summer or early fall when grubs are actively feeding, ensuring maximum exposure to the bacteria.
Persuasively, the cumulative benefits of milky spore extend beyond the garden. By reducing chemical runoff, it protects local waterways and aquatic ecosystems. Japanese beetle infestations can decimate crops and ornamental plants, but milky spore’s preventive approach mitigates this without introducing toxins into the food chain. For families, this means safer outdoor spaces for children and pets. While initial costs may be higher than chemical treatments, the decades-long efficacy makes it a cost-effective investment in environmental stewardship.
Descriptively, imagine a garden where ladybugs, bees, and birds flourish alongside thriving plants, undisturbed by chemical residues. Milky spore fosters this harmony by addressing the root cause of beetle damage without disrupting the web of life. Its granular form is easy to apply with a spreader, and its dormant state ensures it remains viable until conditions are right for activation. For those committed to sustainable practices, it’s a tool that aligns with the principles of regenerative gardening, nurturing both the soil and the broader ecosystem.
Do Gymnosperms Produce Spores? Unveiling Their Unique Reproductive Process
You may want to see also
Frequently asked questions
Yes, milky spore is effective in controlling Japanese beetle grubs, the larvae stage of the pest. It is a biological pesticide that specifically targets these grubs, reducing their population over time.
Milky spore can take 2-3 years to establish itself in the soil and show significant results. Patience is key, as it works gradually to build up beneficial bacteria that combat the grubs.
No, milky spore is safe for beneficial insects, pets, and humans. It is a natural, non-toxic solution that specifically targets Japanese beetle grubs without affecting other organisms.